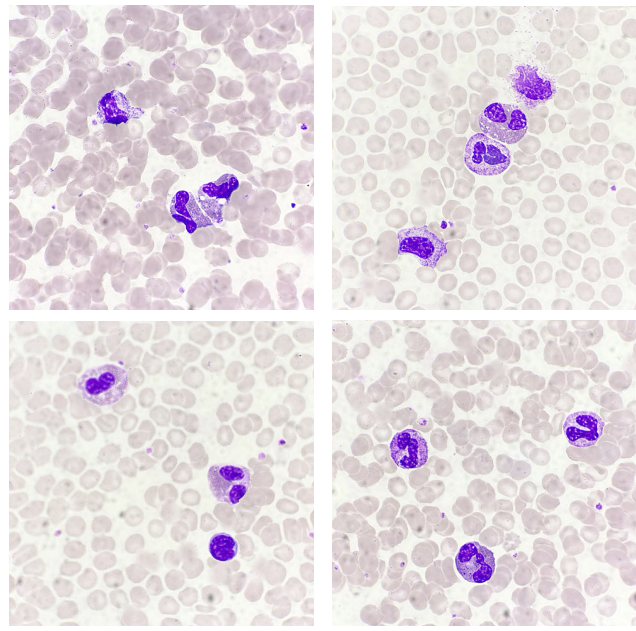

| 前 言
每一種罕見病例,會以某種特殊的臨床癥狀或某個項目異常表現(xiàn)出來,追蹤這樣的病例,可以讓我們的臨床思維變得開闊,對于嗜酸性粒細(xì)胞異常增高,除了寄生蟲感染、過敏、哮喘、腫瘤,你還想到了什么?
案例經(jīng)過
患者男,17歲,以全身淋巴結(jié)無痛性腫大4年余就診。
患者4年前無明顯誘因出現(xiàn)無痛性淋巴結(jié)腫大,最大約鴿蛋大小,無局部發(fā)紅、破潰、滲出,無咳嗽、咳痰、發(fā)熱、頭痛等前驅(qū)感染癥狀,無皮下出血、盜汗,未與重視。曾于外院就診,外院診斷淋巴結(jié)炎,未與治療,20天前因淋巴結(jié)進(jìn)一步增大來我院門診就診,行右頸部淋巴結(jié)穿刺活檢,未見明確惡性證據(jù),門診擬“淋巴結(jié)增大(查因)”入院。
入院檢查雙耳前、耳后、頸前、頸后、腹股溝皆可扣及淋巴結(jié)腫大,質(zhì)軟,界清,易推動,部分融合。當(dāng)遇到這樣一份血液細(xì)胞形態(tài)(骨髓+外周血)送檢單時,筆者首先想到的是—淋巴瘤。在鏡檢時,淋巴細(xì)胞易見,未見典型的淋巴瘤細(xì)胞,取而代之的是較多的嗜酸性粒細(xì)胞,見圖1~2:

血液細(xì)胞形態(tài)(骨髓+外周血)結(jié)果見圖3:
血片意見:白細(xì)胞不少,嗜酸性粒細(xì)胞增高,異型淋巴細(xì)胞4.0%,成熟紅細(xì)胞大小不一,可見小紅、大紅紅細(xì)胞,血小板同骨髓。
骨髓細(xì)胞學(xué)意見:骨髓增生活躍,嗜酸性粒細(xì)胞增高,可見分類不明細(xì)胞,請結(jié)合臨床,骨髓細(xì)胞學(xué)檢查初步排除淋巴瘤骨髓浸潤及血液病可能。患者的嗜酸性粒細(xì)胞升高與全身淋巴結(jié)腫大有必然的聯(lián)系么?當(dāng)患者出院后,查閱了患者的相關(guān)實驗檢查,見圖4:
IGE:5919 IU/mL↑,血常規(guī)嗜酸性粒細(xì)胞:30.7%↑,骨髓活檢嗜酸性粒細(xì)胞易見,結(jié)合實驗檢查結(jié)果及患者臨床癥狀,出院診斷:木村病.
案例分析
木村病,也被稱為Kimura病,是一種非常少見的、病因不明且進(jìn)展緩慢的良性疾變。常發(fā)生與面頸部,臨床表現(xiàn)為皮下多發(fā)慢性無痛腫塊,同時伴外周血嗜酸性粒細(xì)胞及免疫球蛋白E(IgE)升高。最早由我國學(xué)者金顯宅于1937年以“嗜酸性粒細(xì)胞增生性淋巴肉芽腫”進(jìn)行報道,1948年,日本學(xué)者木村詳細(xì)闡述了該病,并將其命名為不同尋常性淋巴組織增生性肉芽腫,這種疾病后來稱為木村病[1]。
木村病多見于亞洲男性,男女比例4:1,在小于20歲的患者中,男女比例更是接近17:1。該病較少見,臨床表現(xiàn)缺乏特異性,容易造成漏診及誤診。
該病與IgE介導(dǎo)的Ⅰ型變態(tài)反應(yīng)有關(guān),患者主要表現(xiàn)為頭頸部皮膚或皮下的緩慢增長的結(jié)節(jié),以腮腺區(qū)最為多見,頜下腺區(qū)、耳前、眼眶、腋窩、腹股溝也可見,伴隨外周血嗜酸性粒細(xì)胞及IgE水平的升高,局部病變大小與嗜酸性粒細(xì)胞密切相關(guān)。
木村病患者的血液細(xì)胞形態(tài)(骨髓+外周血)的相關(guān)資料較少,文獻(xiàn)報道 一例木村病骨髓象[2]。其骨髓象嗜酸性粒細(xì)胞與淋巴細(xì)胞增高,分別為:11.5%、35.5%,本案例骨髓象嗜酸性粒細(xì)胞與淋巴細(xì)胞分別為19.0%、31.0%,骨髓中的嗜酸性粒細(xì)胞以嗜酸性分葉核為主,占比16.0%,部分嗜酸性粒細(xì)胞胞漿內(nèi)顆粒增多增粗,形態(tài)與外周血大致相同。其骨髓象改變與病理檢查相一致,均提示嗜酸性粒細(xì)胞升高,本案例骨髓象與文獻(xiàn)報道相一致。
木村病的診斷主要靠病理學(xué)檢查,檢驗科相關(guān)的實驗室檢查可起到一定的提示作用,如外周血嗜酸性粒細(xì)胞、IgE水平升高。結(jié)合患者的臨床癥狀及其他實驗室檢查如B超,可考慮木村病可能。其特征性3大表現(xiàn)為頭頸部無痛性皮下結(jié)節(jié)、外周血嗜酸性粒細(xì)胞增多和血清IgE升高。
心得體會
嗜酸性粒細(xì)胞增多常見于過敏性疾病及寄生蟲感染,為T淋巴細(xì)胞介導(dǎo)的嗜酸性粒細(xì)胞反應(yīng)性增多,亦常見于某些惡性腫瘤、骨髓增生性疾病。
在自己所在的醫(yī)院,挖了十年嗜酸性粒細(xì)胞的升高,挖到了寄生蟲感染,挖到了惡性腫瘤,挖到了過敏。但是對于木村病,沒挖到,腦中一片空白。進(jìn)修期間,每挖出一例少見病,回顧疾病的診療路徑,檢驗項目在這個疾病的診斷發(fā)揮了什么樣的價值,當(dāng)再次偶遇它時,從檢驗項目的蛛絲馬跡中給臨床醫(yī)生提供最有價值的信息,進(jìn)修的意義與價值正在于此。
2023-9-6 |